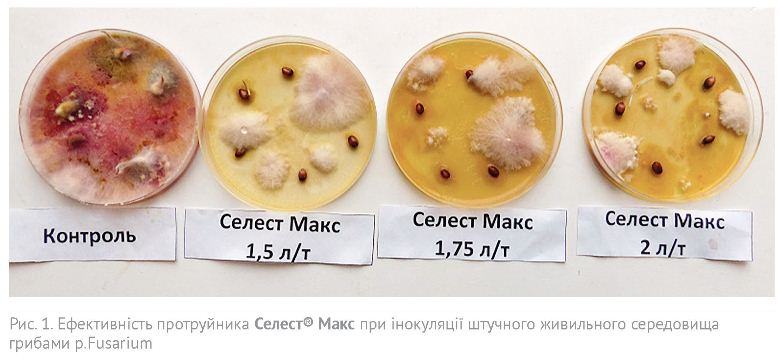

Два роки тому компанія Сингента запропонувала сільгоспвиробниками новий трикомпонентний протруйник для зернових колосових культур - Селест® Макс 165 FS, розроблений спеціально для умов України.До складу препарату входять флудиоксоніл 25 г/л, тебуконазол 15 г/л і тіаметоксам 125 г/л.
С. ЧОНІ, В. ГОЛУБКА
ТОВ «Сингента»
Препарат посів гідне місце в системі захисту зернових культур України, і сьогодні ми можемо говорити про певні досягнення у його застосуванні. Перше питання — це наскільки він збалансований для умов України.
Селест® Макс містить дві фунгіцидні діючі речовини контактної і системної дії. Флудиоксоніл впливає на утворення клітинних мембран і синтез амінокислот грибів. Ця властивість фенілпіролів забезпечує унікальну біологічну ефективність. Фенілпіроли — хімічна група, яка існує на ринку Європи тільки у складі протруйників, тому використання цієї діючої речовини — неодмінний складник антирезистентної програми захисту рослин від хвороб.
Крім того, флудиоксоніл дозволяє максимально ефективно захищатися від грибів роду Fusarium. Саме тому він користується таким попитом у Європі: 30 % насіння зернових колосових культур протруюють препаратами, які містять флудиоксоніл. Порівняно з іншими відомими препаратами з перевіреною ефективністю, які давно представлено на ринку України, у протруйнику Максим® Стар вміст флудиоксонілу збільшено в 1,35 разу. Це не дозволяє сформувати стійкі до конкретної діючої речовини раси патогенів.
Тебуконазол має чітко виражену системну дію — він проникає у кореневу систему, проросток і надземну частину рослини. У зародку діюча речовина знищує сажкову інфекцію, потім переміщується до точки росту, де захищає сходи і кореневу систему від ураження ґрунтовими патогенами. Головна перевага тебуконазолу на фунгіцидному ринку — максимальна ефективність проти сажкових хвороб (і твердої, і летючої). Довгий час сажкові хвороби на території України майже не проявлялися, і нам здалося, що ми навчилися їх контролювати. Проте нині сажкові хвороби дедалі частіше дають про себе знати, проявляються у різних регіонах та залишають по собі нові раси й патотипи.
Поєднання двох названих діючих речовин дозволяє контролювати 95 % насіннєвої інфекції зернових колосових культур.
Протягом двох років ми проводили лабораторні і польові досліди, вивчаючи ефективність протруйника Селест® Макс порівняно з основними конкурентами на українському ринку. На рис. 1 показано вивчення ефективності захисту різних концентрацій цього протруйника при інокуляції штучного живильного середовища грибами роду р. Fusarium. Культивування проходило в умовах, оптимальних для розвитку патогену: температура +18 °С, відносна вологість 80-90 %. На фото представлено 12-денну культуру. Як бачимо, при всіх концентраціях ефективність проти фузаріозу відмінна, особливо порівняно з контролем.
На рис. 2 показано польовий дослід з вивчення ефективності захисту протруйника Селест® Макс (н. в. 1,75 л/т) порівняно з основним інсекто-фунгіцидним конкурентом при внесенні штучного інфекційного фону грибів р. Fusarium у поверхневий шар ґрунту після висіву насіння. Обліки ефективності проводилися рано навесні. За їх результатами ефективність Селест® Макс у 8,2 разу перевищила конкурента.

Ще момент, на який хочеться звернути уваги після двох років спостережень. Сьогодні дедалі частіше постає питання захисту озимої пшениці від збудника септоріозу (Stangonospora nodorum Berk). Патоген стає агресивнішим, завдає більшої шкоди і восени, і рано навесні. Два роки ми спостерігали відсутність симптомів розвитку септоріозу на озимій пшениці, обробленій протруйником Селест® Макс восени чи рано навесні у фазі кущення — перше міжвузля культури.
Нині неможливо отримати добрий урожай озимих і ярих без використання інсектициду у складі протруйника. Комплекс комах, які шкодять посівам озимої пшениці і ячменю з осені, такий широкий, що передбачити всі чинники неможливо. Це і багатоїдні ґрунтові шкідники — дротяники, несправжні дротяники (рис. 3), хлібний турун (рис. 4), хрущі тощо; прихованоживучі шкідники — злакові мухи (рис. 5), стеблова хлібна блішка; сисні шкідники — попелиці, цикадки, трипси тощо.
Тіаметоксам — високосистемна діюча речовина, яка швидко проникає у рослину і переміщується по судинній частині, максимально концентруючись у меристемах (точках росту проростка або кореня). У такий спосіб вона захищає підземну і надземну частини рослин від ґрунтових сисних і прихованоживучих шкідників. Діюча речовина активує також синтез антистресових білків у проростках. З цим пов’язано ефективну стимуляцію росту — так званий Vigor®-ефект, який виражається у швидкому старті, накопиченні підземної маси та підвищенні врожайності.
Формуляцію протруйника Селест® Макс розроблено з урахуванням новітніх досягнень у галузі захисту рослин, називається вона Формула М. Завдяки зниженню абразивності обробленого насіння істотно зменшується кількість пилу, а це означає безпечніші умови праці персоналу, менше часу на очищення обладнання, зменшення піноутворення і зручність під час приготування робочого розчину. А ще це краще покриття насіння для забезпечення максимальної ефективності, навіть в екстремальних умовах, інтенсивніше забарвлення для кращого візуального контролю. Щоб максимально заощадити ваші витрати, технологія Формула М гарантує, що препарат буде там, де він і має бути, — на насінні.
Досліди на території України підтверджують беззаперечну ефективність протруйника Селест® Макс. Застосування цього препарату збільшує коефіцієнт кущення озимої пшениці після зимівлі у 2,2-3,1 разів.
Досліди проводилися на озимій пшениці і ярому ячмені. Особливої уваги заслуговує стимулюючий ефект протруйника на розвиток кореневої системи і рослини взагалі. Це важливий чинник і для озимих, і для ярих культур. Для озимих це передусім покращення зимівлі та стимуляція виникнення додаткових бічних пагонів восени і рано навесні. Для ярих культур — можливість протистояти стресам у період екстремальних весняних умов.
Отже, Селест® Макс забезпечує надійний збалансований захист від комплексу основних шкідників і хвороб на початковому етапі росту рослин. Використання протруйника в рекомендованих нормах дозволяє повністю реалізувати потенціал зернових культур завдяки захисному і фізіологічному ефектам. Ефективність компонентів, які входять до складу препарату, перевірено часом і досвідом, вона повністю відповідає антирезистентним програмам.